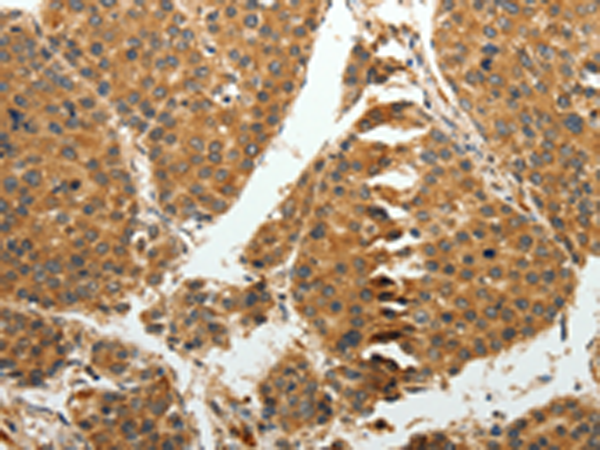

中文名稱:兔抗RRM1多克隆抗體
英文名稱: Anti-RRM1 rabbit polyclonal antibody
別 名: R1; RR1; RIR1
儲 存: 冷凍(-20℃)
宿 主: Rabbit
抗 原: RRM1
相關(guān)類別: 一抗
反應(yīng)種屬: Human, Mouse
標(biāo)記物: Unconjugate
克隆類型: rabbit polyclonal
Background:
This gene encodes one of two non-identical subunits that constitute ribonucleoside-diphosphate reductase, an enzyme essential for the production of deoxyribonucleotides prior to DNA synthesis in S phase of dividing cells. It is one of several genes located in the imprinted gene domain of 11p15.5, an important tumor-suppressor gene region. Alterations in this region have been associated with the Beckwith-Wiedemann syndrome, Wilms tumor, rhabdomyosarcoma, adrenocrotical carcinoma, and lung, ovarian, and breast cancer. This gene may play a role in malignancies and disease that involve this region.
Applications:
ELISA, WB, IHC
Name of antibody:
RRM1
Immunogen:
Fusion protein of human RRM1
Full name:
Ribonucleotide reductase M1
Synonyms:
R1; RR1; RIR1
SwissProt:
P23921
ELISA Recommended dilution:
1000-2000
IHC positive control:
Human liver cancer and human tonsil
IHC Recommend dilution:
25-100
WB Predicted band size:
90 kDa
WB Positive control:
Hela and 231 cells
WB Recommended dilution:
200-1000
技術(shù)規(guī)格

購物車
購物車 幫助
幫助
 021-54845833/15800441009
021-54845833/15800441009
